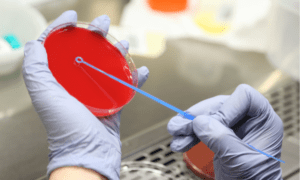
Método de identificación bacteriana en el entorno clínico actual

Método de identificación bacteriana en el entorno clínico actual
El método de identificación bacteriana es una herramienta fundamental dentro del ámbito sanitario y de laboratorio, ya que permite reconocer y diferenciar microorganismos responsables de múltiples procesos infecciosos. En este blog hablaremos de los principales enfoques utilizados para detectar bacterias, cómo se visualizan y cuáles son los métodos más actuales empleados en microbiología, siempre desde … Sigue leyendo Método de identificación bacteriana en el entorno clínico actual